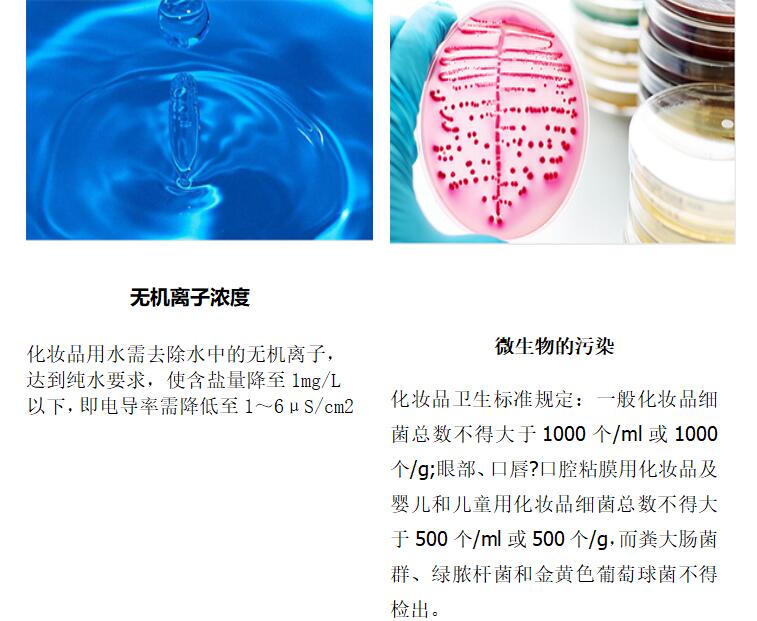

一站式服务 为您解决水处理设备问题
20多年水处理设备行业经验




中业环保作为一家15年行业经验的工程定制厂家,致力于工业纯水系统一站式
解决方案
成功应用在20个行业100+项工业用水的高效率处理工程

面临问题

纯化水系统严格经过30余道工序匠心制造,工程模块,均可采用现场组装,可升级,可移动





